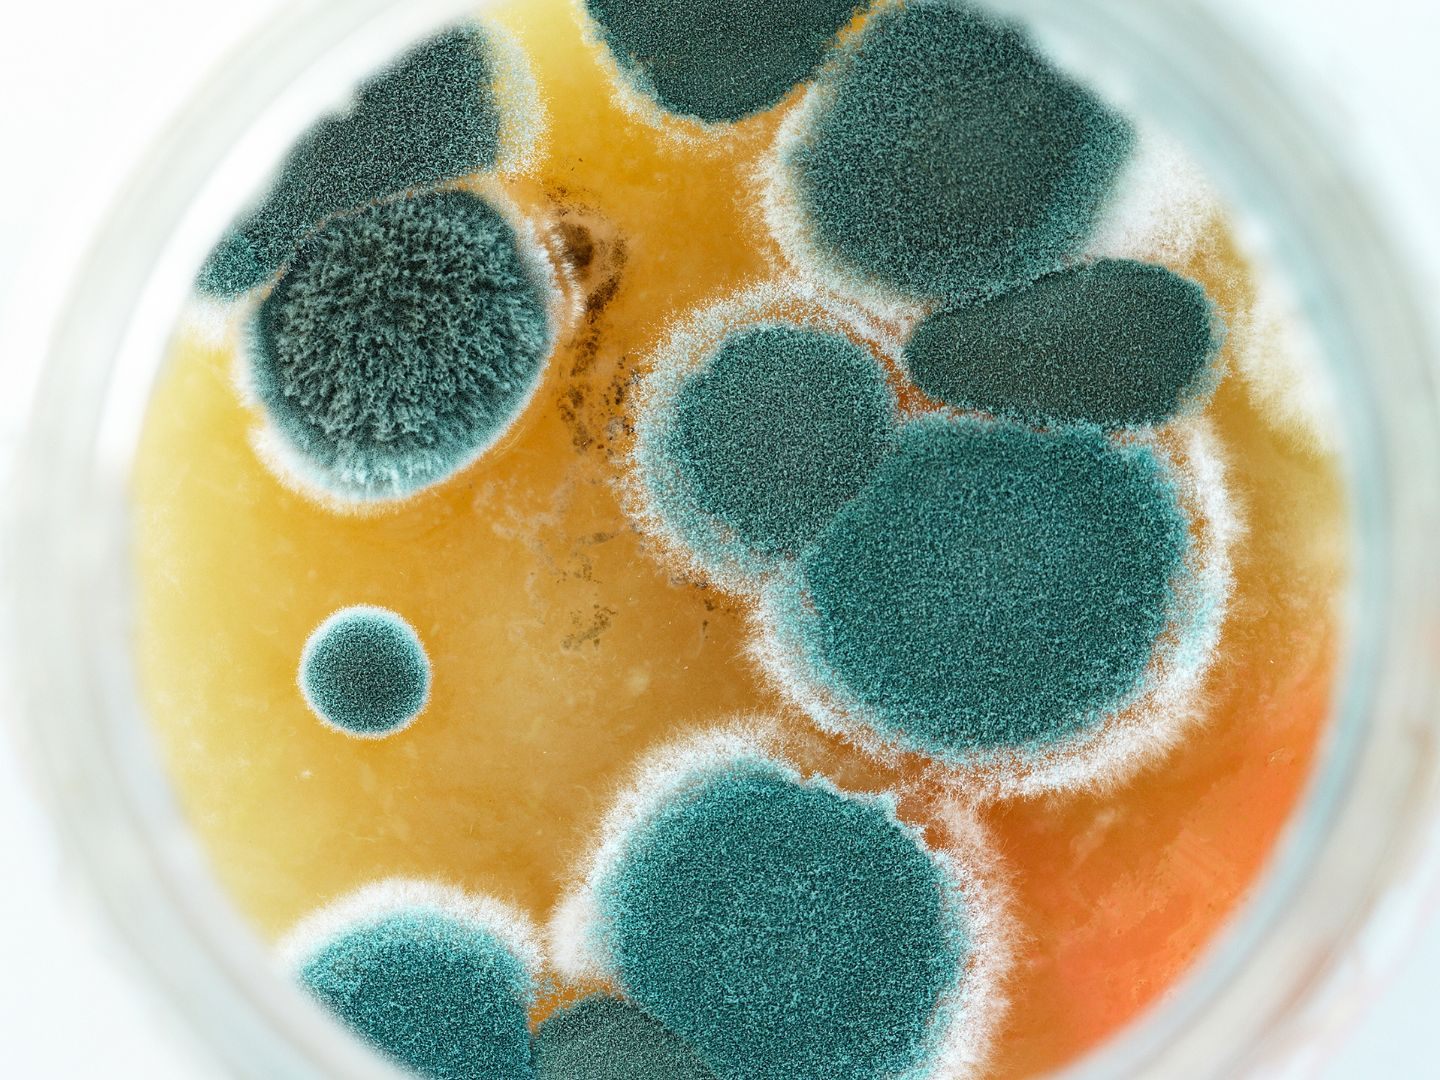

Bakterien & Schimmel: Fünf häufige Gegenstände, die im Bad nichts verloren haben
Im Badezimmer herrschen hohe Temperaturen und eine hohe Luftfeuchtigkeit. Das ist für viele Produkte problematisch. Vor allem diese fünf Dinge sollten auf keinen Fall im Bad gelagert werden.
- Make-Up und Pinsel
- Parfums
- Modeschmuck
- Sonnencreme
- Medikamente
Make-Up und Pinsel drohen angesichts der Gegebenheiten im Badezimmer zu Bakterienherden zu werden, Parfums verlieren bei hohen Temperaturen ihren Duft, Modeschmuck oxidiert schnell und verliert seinen Glanz, Sonnencreme verliert die Wirksamkeit und droht zu schimmeln und auch Medikamente verlieren ihre Wirksamkeit. Mehr dazu im folgenden Video.
(Red.)
Du hast einen Hinweis für uns? Oder einen Insider-Tipp, was bei dir in der Gegend gerade passiert? Dann melde dich bei uns, damit wir darüber berichten können.
Wir gehen allen Hinweisen nach, die wir erhalten. Und damit wir schon einen Vorgeschmack und einen guten Überblick bekommen, freuen wir uns über Fotos, Videos oder Texte. Einfach das Formular unten ausfüllen und schon landet dein Tipp bei uns in der Redaktion.
Alternativ kannst du uns direkt über WhatsApp kontaktieren: Zum WhatsApp Chat
Herzlichen Dank für deine Zusendung.